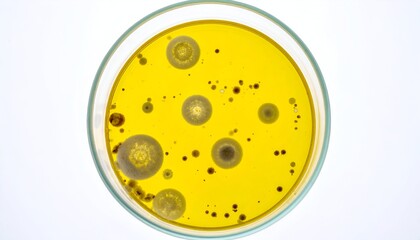
Fototapeta premium A petri dish, showcasing colonies of various colors and shapes in a yellow medium

RABAT DO 40% - wygasa 12.03 !!! | Darmowa dostawa od 290zł | Potrzebujesz pomocy? Zadzwoń 22 678 07 67
(0)
Produkt dodany poprawnie do Twojego koszyka
Ilość
Razem
Ilość produktów w Twoim koszyku: 0. Jest 1 produkt w Twoim koszyku.
Razem produkty:
Dostawa: Do ustalenia
Razem
Kontynuuj zakupy Przejdź do realizacji zamówienia
Start > Fototapeta premium
Jakiego obrazu szukasz?
Użyj wyszukiwarki i szukaj wśród milionów zdjęć.
Fototapety Fototapeta premium
- #1316530862
- #833824762
- #1625488652
- #378726319
- #586922617
- #95067648
- #1625488989
- #1327367131
- #1099357307
- #1606615446
- #1641315085